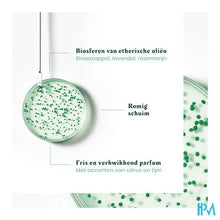
Load image into Gallery viewer, Furterer Forticea Versterkende Revitalis. Sh 200ml

Plus d'informations
Utilisation
Breng aan op een natte hoofdhuid en masseer zachtjes met cirkelvormige bewegingen. Laat gedurende 1 tot 3 minuten inwerken. Spoel uit.
Description
De verstevigende en revitaliserende shampoo FORTICEA is geschikt voor alle haartypes. Het combineert Guarana, een krachtige natuurlijke energizer, met vitamine B5 en B3 of niacinamide, en met de kostbare krachten van een cocktail van stimulerende essentiële oliën, samengebracht in kleine bolletjes. Het geheel is ideaal om de kracht van het haar een boost te geven. De toevoer van vitaminen en energie-elementen wordt vanaf de wortel geïntensiveerd. Het resultaat is een sterkere, meer resistente en mooiere haarvezel. Het haar is sterker, gezond en bruist elke dag weer van de energie. Luchtig aanvoelend en gemakkelijk te stylen haar dat perfect in model blijft. Bestaat voor 97% uit bestanddelen van natuurlijke oorsprong. Vrij van siliconen en gesulfateerde oppervlakteactieve stoffen. Biologisch afbreekbare formule*. *Volgens OESO301B.
Caractéristiques
• MILDE REINIGENDE WERKING: de formule is rijk aan stimulerende en zuiverende essentiële oliën. • BRON VAN KRACHT EN STERKTE: Versterkt het haar dag na dag, met sterker en makkelijker te stylen haar als resultaat. • EEN ZINTUIGPRIKKELENDE BELEVING: het haar wordt omhuld met een verkwikkende geur van bruisende noten.
Composition
WATER (AQUA)*. LAURYL GLUCOSIDE*. SODIUM COCOYL ALANINATE*. COCO-BETAINE. AGAR*. ALGIN*. BENZOIC ACID. CAFFEINE. CALCIUM GLUCONATE. CELLULOSE*. CELLULOSE GUM*. CHROMIUM HYDROXIDE GREEN (CI 77289). CHROMIUM OXIDE GREENS (CI 77288). CITRIC ACID*. CITRUS AURANTIUM DULCIS (ORANGE) OIL (CITRUS AURANTIUM DULCIS OIL)*. FRAGRANCE (PARFUM). GLUCONOLACTONE*. GLYCERIN*. GREEN 3 (CI 42053). HYDROXYPROPYL GUAR HYDROXYPROPYLTRIMONIUM CHLORIDE. LAVANDULA ANGUSTIFOLIA (LAVENDER) OIL (LAVANDULA ANGUSTIFOLIA OIL)*. LAVANDULA HYBRIDA OIL*. LIMONENE*. LINALOOL*. MALTODEXTRIN*. METHYL GLUCOSE DIOLEATE. NIACINAMIDE. PANTHENOL. PANTOLACTONE. PAULLINIA CUPANA SEED EXTRACT*. PROPANEDIOL. ROSMARINUS OFFICINALIS (ROSEMARY) LEAF OIL (ROSMARINUS OFFICINALIS LEAF OIL)*. SODIUM BENZOATE. TALC. TOCOPHEROL. TOCOPHERYL ACETATE. YELLOW 5 (CI 19140)